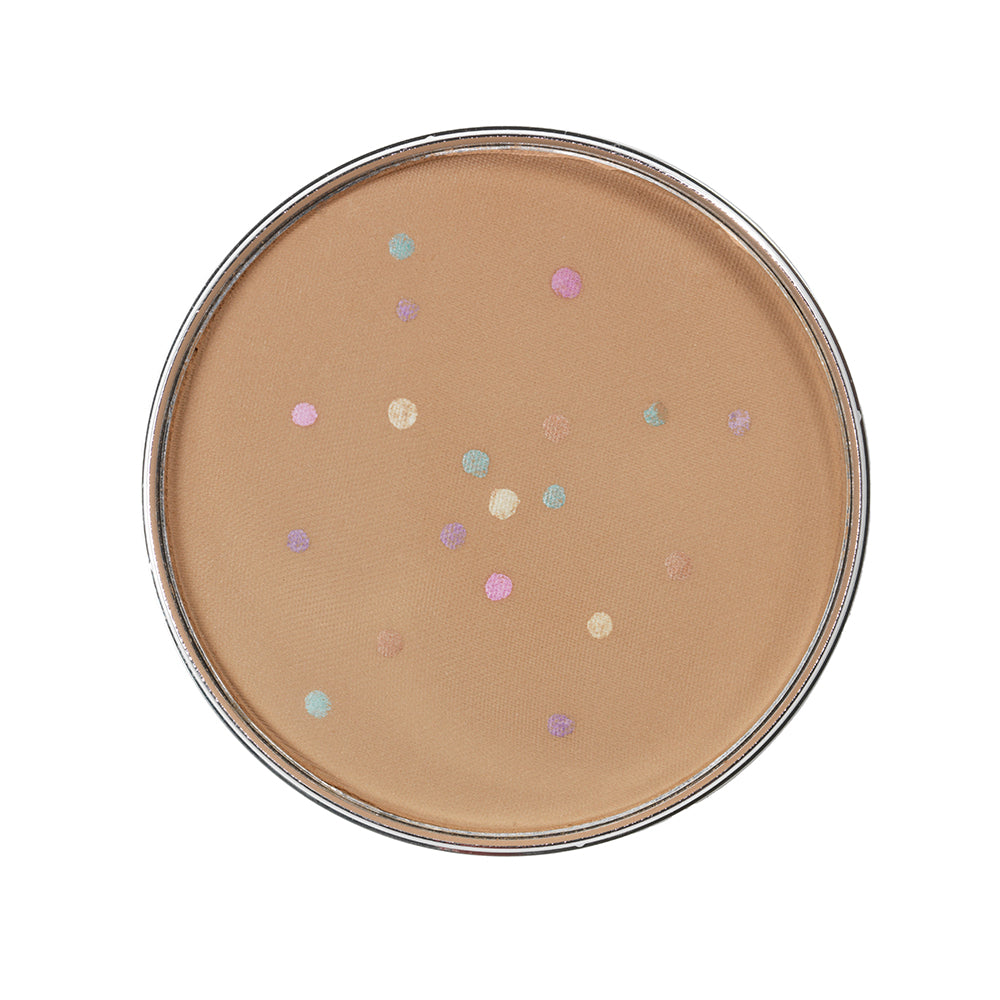
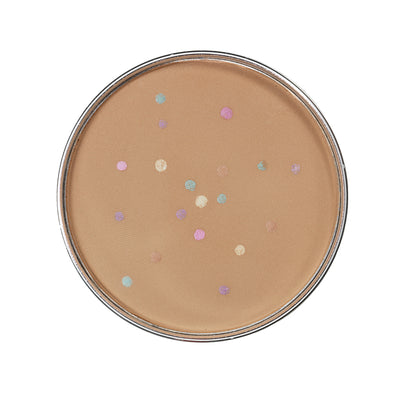

Stackables Magic Minerals Powder Foundation
Color:Medium Dark
Quantity:
Order now and get it within 5 days*
*Delivery times may vary based on state
- Free shipping on orders $49+
- Easy Returns
- Compact powder foundation for a smooth matte finish
- Adjusts to your skin tone
- 4 color pigments conceal, cover, and correct
- Sets makeup for 12-hour wear
- Combine with other Stackables to build your own makeup stack
- Skincare actives protect and nourish
Jerome recommends
Jerome recommends
Total:
$00.00
Stackables Magic Minerals Powder Foundation
$14.00
AirPrimer Liquid Silk Makeup Primer
$24.00

Kabuki Foundation Brush
$22.00
Total:
$00.00


Get the details

Get the VIP treatment
- Finish faster: Let AirBrush Foundation glide onto your skin for a natural, smooth, and streak-free finish.
- Buildable coverage: Build ultrafine layers to get the coverage you want. You’re in charge!
- Skin support: Live your best life while our unique blend of active ingredients seals in moisture and evens out fine lines.
- Timeless beauty: Look your best until bedtime with a foundation that stays put all day, even in the face of sweat and humidity.
- Lighter impact: Choose a foundation that treads as lightly as it feels. Cans are recyclable and formulas are paraben, phthalate, and cruelty-free.


Skin indulgence
Our formula delivers more than just an instant glow thanks to Jerome’s proven blend of nourishing skin actives. Just one spray gives you immediate radiance and long-term beauty-preserving benefits.
- Hyaluronic acid seals in moisture and keeps your makeup looking fresh.
- Argireline supports elasticity to pause time on your skin.
- Matrixyl 3000 softens fine lines, rejuvenating skin from within.